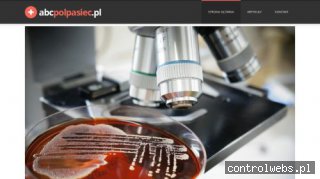
Półpasiec

Półpasiec
ID wpisu: 12915
Dodano: 17.01.2014
Kliknięć: 0
Wyświetleń: 2543
CTR: 0.00%
739

53

Ocena Controlwebs:
Ocena użytkowników:
Adres: http://abcpolpasiec.pl
(strona nie działa lub występuje inny problem? zgłoś awarię)
Opis: Niniejsza strona to bardzo przystępnie napisany przewodnik po chorobie, jaką jest półpasiec. Witryna opisuje, czym jest ta choroba oraz w jaki sposób można ją rozpoznać. Na stronie znajdziemy też opisane dokładnie rodzaje tego schorzenia. Witryna wyjaśnia nam też, jakie są przyczyny powstawania półpaśca. Na stronie znajdziemy również opisane sposoby diagnozowania tego schorzenia. Witryna podejmuje też takie ważne zagadnienie jak półpasiec w ciąży – wyjaśnia czy i na ile jest on groźny dla przyszłej mamy. Poza tym znajdziemy na stronie również omówione szczegółowo zagadnienie, jakim jest półpasiec postacie. Witryna opisuje też jak wygląda półpasiec u dzieci.
Kategorie:
Podlinkuj stronę: abcpolpasiec.pl
Opinie o stronie abcpolpasiec.pl (0)
Można wpisać maksymalnie 255 znaków. Pozostało 255 znaków.
Podobne strony w katalogu
Gabinet Okulistyczny przy Pracowni Optycznej Bożenny Ławrynowicz oferuje wykonywanie specjalistycznych badań wzroku oraz precyzyjne wyznaczanie możliwych (...)
Prywatny gabinet kardiologiczny Witolda Armady działa w Chojnicach od 1988 r. Jednostka proponuje przeprowadzenie nieinwazyjnych badań kardiologicznych (...)
Ta strona adresowana jest do wszystkich, którzy zetknęli się z chorobą, jaką jest zapalenie cewki moczowej. Witryna opisuje szczegółowo, na czym (...)
Atopowe zapalenie skóry jest wyjątkowo częstą chorobą zapalną skóry. "Atopia" wiąże się z nadmiernie wysoką podatnością do przypadłości (...)
Ta strona ma za zadanie przybliżyć nam tematykę związaną z substancją leczniczą, jaką jest acyklowir. Na witrynie zostały podjęte takie tematy (...)
Niedoczynnosc-tarczycy.pl to połączenie fachowej wiedzy o niedoczynności tarczycy z doświadczeniem w jej leczeniu. Posiadaną wiedzę pragniemy przekazać (...)
Ten dedykowany dziedzinie zdrowia blog przeznaczony jest głównie dla czytelników, którzy odczuwają potrzebę zadbania o swój organizm, utrwalenia (...)
Łysienie androgenowe jest najczęściej spotykane, co więcej mało kto by miał problem wypadających włosów gdyby nie jedna drobnostka. Jest nią (...)
Tak zwane reumatoidalne zapalenie stawów jest chorobą autoimmunologiczną czyli taką która powoduje, że Twój własny organizm atakuje zdrowe tkanki. (...)
